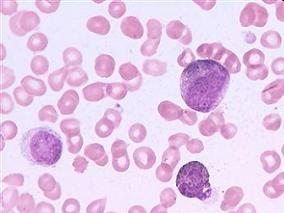
中等剂量环磷酰胺治疗SAA有明显毒性且不能阻止复发

-
青春期矮小男性治疗:来曲唑 vs 阿那曲唑
环球医学资讯
2014年12月03日
点击量:6561
1小时条评论青春期男孩的身材矮小治疗中,经常标示外使用芳香化酶抑制剂。2014年11月,在线发表在《J Clin Endocrinol Metab》的一项研究对接受来曲唑(L)或阿那曲唑(A)治疗的青春期矮小男性的短期和长期激素和发育差异进...
-
肢端肥大症治疗:手术比药物可能更有效
环球医学资讯
2014年12月03日
点击量:336
1小时条评论手术通常作为肢端肥大症的一线治疗方法,而药物治疗也可作为一种主要的替代治疗方法。这两种方法的有效性如何呢?2014年11月,发表在《J Clin Endocrinol Metab》的一项系统评价和Meta分析对此进行研究。 背景:...
-
吸入抗生素:干粉还是雾化?
环球医学资讯
2014年12月28日
点击量:506
1小时条评论针对铜绿假单胞菌(绿脓杆菌)感染治疗的吸入抗生素领域的发展为该菌引起的疾病的治疗、控制以及患者寿命的延长做出了巨大贡献。目前,囊性纤维化患者通过干燥粉末吸入器(DPIs)吸入抗生素抑制铜绿假单胞菌的治...
-
低或中度风险APL患者可首选ATRA+三氧化二砷作为一线…
环球医学资讯
2012年05月14日
点击量:330
1小时条评论急性早幼粒细胞白血病发病急,若不治疗病人常于半年内死亡。2014年10月发表在《J ClinOncol.》的一项由意大利和德国科学家进行的研究表明,当前HRQOL发现进一步支持在低或中度风险APL患者中,首选ATRA+三氧化二砷...
-
中等剂量环磷酰胺治疗SAA有明显毒性且不能阻止复发
环球医学资讯
2012年05月14日
点击量:244
1小时条评论环磷酰胺为最常用的烷化剂类抗肿瘤药,还具有显著免疫抑制作用。2014年10月发表在《Blood》的一项由美国和巴西科学家进行的研究表明,中等剂量环磷酰胺治疗SAA有明显毒性,且不能阻止复发。 重度再生障碍性贫血...
-
处方药物调剂的全国性评估
环球医学资讯
2014年11月19日
点击量:334
1小时条评论2014年10月,发表在《Pharmacotherapy》的一篇文章描述了美国处方开具者调配处方药物和非处方药物的合法性、专业性和消费者状态。 目的:旨在描述美国处方开具者调配处方药和非处方药物的合法性、专业性和消费者...
-
参加药师提供的电话MTM项目的医疗补助患者中MRPs的…
环球医学资讯
2014年12月19日
点击量:353
1小时条评论2014年10月,在线发表在《Pharmacotherapy》的一项回顾性分析对参加药师提供的电话药物治疗管理项目(MTM)的医疗补助患者中药物相关问题(MRPs)的预测因素进行鉴别。 研究目的:旨在鉴别参加药师提供的电话药...
-
药学学生对于合理使用抗生素的知识和态度
环球医学资讯
2014年11月12日
点击量:298
1小时条评论药剂师为抗菌药物管理的主要合作伙伴。2014年10月,发表在《Clin Infect Dis.》上的一项研究显示,药学生认为抗生素药物管理是一个重要的医疗保健问题,并希望在该问题上获得更多的教育。 摘要:药剂师为抗菌药...
-
美国人群中晚期甲氨喋呤相关肝病的负担可能是非常小的
环球医学资讯
2014年11月12日
点击量:401
1小时条评论在2014年10月的《Aliment Pharmacol Ther.》杂志中,一篇文章介绍了甲氨喋呤(MTX)是当代药物中最常处方的药物之一。晚期甲氨蝶呤相关的肝脏疾病是罕见的并与代谢综合征的特点有关。因其肝毒性而出名,提倡需要...
-
药师提供的MWV在经济上是可行的
环球医学资讯
2014年11月05日
点击量:260
1小时条评论2014年8月,发表在《J Am Pharm Assoc》的一篇文章描述了药师提供的医疗保险年度健康访问(MWV)的发展和实施。结果表明,药师提供的MWV在经济上是可行的,并且允许更多的药师参与到基础医疗团队中。 目的:旨在...

会员登录


网友评论
Yvette05-22
脱发一直是很多人的困扰,希望能广泛应用。
Ada305-22
补碘知识非常全面,获益匪浅。
penelope05-22
“盐重”问题确实需要重视